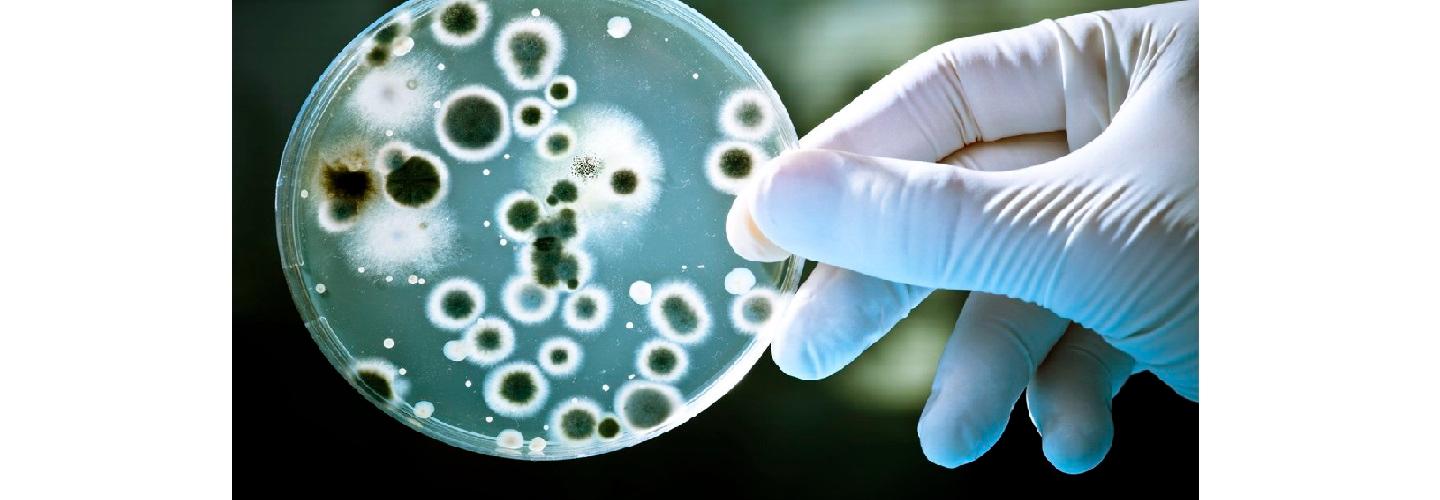
Mold Solutions & Inspections cover photo

Mold Solutions & Inspections
About Business
Would you like to learn more about mould solutions and inspections? Wearemsi.com offers mould inspection and water damage restoration services in Portland, Oregon. If you require any additional information, contact us.
Other Businesses

Damage Restoration
Flooded.com

Damage Restoration
Peak Northwest Restoration

Damage Restoration
Service Pro Restoration of Fort Myers

Damage Restoration
Water Damage Pros of California

Damage Restoration
Elite Restoration Group

Damage Restoration
Fire Restoration Houston TX

Damage Restoration
Pittsburgh Water Rescue

Damage Restoration